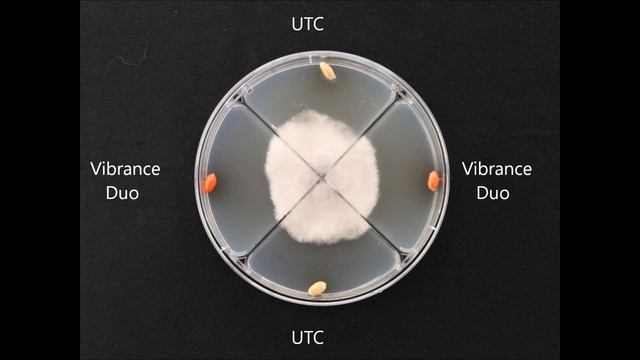
Vibrance Duo Veikimas Nuo  Fusarium Culmorum Kviečiuose Sukeliančios Pašaknio Ir šaknų Puvinius

Грибы: ключи к естественному равновесию - Новые видео
-
-
Juan Eizaguirre - III Congreso De Lúpulo 2018
"Parámetros de Calidad de Lúpulo", por Juan Eizaguirre (IPATEC) _______ III Congreso de Lúpulo, los esperamos en febrero del próximo año para la próxima...
Смотреть -
Самый быстрый и легкий способ маринования грибов, груздей 😋
Грибы кипят 25 минут. Сливаем воду Маринад на 1 литр воды: - 1 столовая ложка соли - 2 чайные ложки сахара - 1 чайную ложку черного перца горошек - 3 ...
Смотреть -
-
-
-
-
-
The Last Of Us™ Remastered Part 1 - NO COMMENTARY
The Last of Us Remastered Gameplay Walkthrough Part 1 Review. This The Last of Us Remastered Gameplay Walkthrough will include a Review, Graphic Compari...
Смотреть -
Can't Get EnoUgh OF YOu.. Belgian Chocolates!
Variety of Chocolates #chocolatier #belgian #chocolates #whenIamin #Belgium
Смотреть -
Gedonia - Прохождение #15 | Ядовитые Болота
Гедония это РПГ с открытым прекрасными миром, который вы свободно можете исследовать без загрузочных экранов, а также создать любой тип персонажа, какой...
Смотреть -
-
-
(216lbs) Flabby Teen Piggy Shows Off His Fattening Body
https://www.patreon.com/charlieking - if you wanna help make me even fatter and flabbier... So yeah, I gained more weight. I’m tired all the time and I...
Смотреть -
Free Giveaway, Probiotics For Bees, World’s Largest Christmas Tree, And Windmills! 11/25/2022
 We’re thankful for our YouTube subscribers! To celebrate achieving over 300 viewers, we are giving away a bag of probiotics for bees. For Thanksgiving...
Смотреть -
【小穎美食】土豆裡加2個雞蛋,教你饞嘴新吃法,酥脆又軟糯,孩子隔三差五想吃
#小穎美 #XiaoyingCuisin #XiaoyingCookin #土豆 今天給大家分享的是土豆各種美味的做法,這個是合集視頻,需要準備:土豆、糯米粉、白糖、糯米粉、紅豆沙、雞蛋、...
Смотреть -
-
Дюп в Minecraft 1.5.2 На серверах!
Оригинал:http://www.youtube.com/watch?v=0iea6nccS54 /cdroptransfer select В нодусе chat /logout
Смотреть -
TAM ÖLÇÜLÜ DİKDÖRTGEN ÇANTA TABANI YAPILIŞI #tığişi#çanta
MALZEMELER: Kağıt ip, 3 numara tığ (3 mm). Dikdörtgen çanta tabanı yapılışı. Çanta tabanı ölçülerini hesaplama. Torba çanta tabanı nasıl örülür. Kağıt ...
Смотреть -